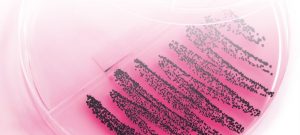

El Síndrome de Dermatitis Ulcerativa en cerdas (PUDS, Porcine Ulcerative Dermatitis Syndrome), hace referencia a un desorden crónico y de aparición esporádica en animales adultos, cuyo origen, sigue sin estar bien definido.
Los estudios y artículos al respecto son pocos y están realizados sobre un número reducido de animales, a menudo solo uno.
- Hay casos descritos desde hace muchos años, pero hoy en día sigue siendo una alteración sobre la que hay muchas lagunas, tanto en lo referente a su etiología y patogénesis como a los factores relacionados. De hecho, su nomenclatura actual fue propuesta en 2004 por Schmoll1 en un artículo en el que se pretendía diferenciarla de la dermatitis ulcerativa de origen bacteriano.
PRESENTACIÓN CLÍNICA DEL PUDS
La presentación clínica de este proceso es muy llamativa, observándose zonas de piel hiperémicas, mayoritariamente en la región mamaria, aunque también pueden presentarse en los flancos, muslos, base de la cola, zona perineal y orejas.
Curiosamente, el pezón no se ve afectado, aunque toda la piel de alrededor sí lo esté y, por tanto, no se compromete su funcionalidad.

Imagen 1. Típica manifestación del PUDS, sin afectación del pezón.

Las áreas afectadas aparecen como úlceras de tamaño variable, con los bordes bien delimitados y delgados, que no sobresalen de la superficie, aunque a veces hay descamación alrededor.
Comienzan como nódulos blanquecinos que terminan ulcerándose, con una forma más o menos redondeada, que acaban confluyendo y extendiéndose.
Los animales presentan una temperatura corporal normal o algo disminuida y se ven bien, quizá algo anémicos en algún caso, y en general mantienen una buena condición corporal.
| Suele verse en animales al final de la gestación o al inicio de la lactación, y las lesiones tienden a desaparecer durante la lactancia o el postdestete, aunque no responden a tratamientos con antibióticos y/o antiinflamatorios. No se ha establecido relación con el ciclo productivo de la cerda. |

Tabla 1. Ejemplo de variedad de ciclos de presentación y temperaturas de los animales afectados, todos ellos en la fase periparto (Fuente propia).

Imagen 4. Cerda lactante afectada con PUDS.
DIAGNÓSTICO DEL PUDS
En este caso, hay que basarse en:



El diagnóstico diferencial debe hacerse con:
» Dermatitis de origen bacteriano (que responderían al tratamiento antibiótico).
» Intoxicación.
» Quemaduras.
» Síndrome de dermatitis y nefropatía.
» Otras patologías mucho menos comunes, como el pénfigo o la epidermólisis.
También deben descartarse las enfermedades vesiculares que afectan al porcino2.
| En el caso de realizar un raspado cutáneo de la lesión, es posible encontrar bacterias ubicuas de la piel, como Staphylococcus hyicus, en baja o media cantidad, sin que tengan importancia clínica en estos casos. |
Histopatología
A nivel histopatológico se describen:
- Áreas de necrosis en la epidermis con zonas ulceradas, bajo las que se observa un infiltrado inflamatorio mixto (linfocitos, neutrófilos y macrófagos).
- Adyacentes a las zonas ulceradas, áreas con hiperplasia del epitelio con hiperqueratosis, células del estrato basal con degeneración hidrópica y queratinocitos apoptóticos en distintos niveles de la epidermis.
- Debajo de las zonas con hiperplasia, infiltrado inflamatorio concentrado en la unión dermoepidérmica, compuesto principalmente por linfocitos3.
Bioquímica
En lo que respecta a los análisis de parámetros bioquímicos, no hay unanimidad en los resultados publicados en la literatura. Un claro ejemplo se muestra en la Tabla 2, donde se obtuvieron resultados distintos en tres artículos diferentes.
Atendiendo a estos datos, se aprecia que aún queda mucho por estudiar en cuanto a los valores hematológicos y bioquímicos de los animales
con PUDS.

Inmunohistoquímica
No se han detectado marcadores de apoptosis3.
En cuanto a los niveles de IgG, se han obtenido resultados distintos dependiendo de la técnica utilizada y del estudio consultado.
» Se describen niveles de IgG determinados por inmunodifusión elevados de dos a cuatro veces en todas las cerdas afectadas en comparación con animales sanos.
» No se han detectado depósitos de IgG utilizando la técnica de inmunofluorescencia (IF) directa y tampoco se pudieron demostrar autoanticuerpos IgG circulantes en muestras de suero mediante un método de IF indirecta en un trabajo de 2016, aunque sí se observó un
patrón lineal de precipitación de IgG a nivel de la membrana basal en otro de 20094,5.
Serología y aislamiento vírico
En todo el material publicado se coincide en que son animales que no presentan resultados compatibles con infecciones activas por virus como PRRSv, PCV2 o PPC, ni con patologías de origen bacteriano como Mal Rojo1,5.
RESOLUCIÓN DE LAS LESIONES ASOCIADOS AL PUDS
El PUDS no responde a ningún tipo de tratamiento. De hecho, ni siquiera se observa efecto tras el tratamiento con corticoides, que
son de elección ante trastornos autoinmunes.
- Generalmente, las lesiones se resuelven solas al cabo de 4-8 semanas, aunque se han descrito recidivas en animales en distintos ciclos consecutivos4.

Imágenes 5, 6 y 7. Resolución de lesiones en vulva en una cerda en 6 semanas.
LEJOS DE CONOCER SU ETIOLOGÍA Y SU CONTROL
Se han descrito en otras especies alteraciones muy similares.
Un ejemplo de ello es el Síndrome de Dermatitis Ulcerosa en perros pastores (Collies y Shetlands), que fenotípicamente es muy similar, con lesiones en la unión dermoepidérmica, aunque se caracteriza por un infiltrado linfocitario. Además, se observa gran cantidad de leucocitos y cristales en orina, con afectación renal.
También existen cuadros clínicos similares en en el ser humano:
» El Penfigoide Gestacional, una patología autoinmune que se manifiesta en el segundo y tercer tercio de la gestación en mujeres, cursando con un prurito intenso.
» La Dermatitis Autoinmune por Progesterona que desencadena una reacción de hipersensibilidad en mujeres durante su ciclo menstrual debido a las fluctuaciones de esta hormona.
Lo que sí está más o menos claro es la relación que tiene el PUDS con la gestación de las cerdas, quizá debido a cambios hormonales o a hitos del desarrollo del embrión y de la propia gestación.
También se han descrito alteraciones autoinmunes que no responden a tratamientos con corticoides a menos que se empleen dosis extremadamente altas, muy por encima de las recomendadas. Y todo esto, entre otros muchos factores, está aún por estudiar.
|
Los casos son muy aislados y, a priori, no parecen afectar al comportamiento del animal ni es contagiosa. Todo ello hace muy difícil su seguimiento, la obtención de muestras y la posibilidad de profundizar en su investigación. Sin embargo, es un campo abierto a quien pueda aportar el más mínimo avance en este sentido. |
BIBLIOGRAFÍA
1. Schmoll F, Sipos W, Kahlbacher H, Schilcher F, Bagó Z, Bunka S, et al. Clinical and pathological features of the Porcine Ulcerative Dermatitis Syndrome (PUDS). J Vet Med [Internet]. 2004;51:15–8. www.blackwell-synergy.com
2. Coignoul FL, Bertram TA, Martineau GP. Pathology of an Ulcerative Dermatitis in Belgian Landrace sows. Vet Pathol. 1985;22:306–10.
3. Sánchez-Giménez P, Sánchez J, Pallarés FJ, Cerón JJ, Ramis G. Atypical Ulcerative Dermatitis in a Spanish farm: a clinical case. ESPHM 2021- 12th European Symposium of Porcine Health Management. 2021.
4. Zeeh F, Suter MM, Mueller E, Brünisholz N, Zimmerman W, Ricklin M, et al. Chronological clinical and pathological documentation of porcine ulcerative dermatitis. Vet Dermatol. Blackwell Publishing Ltd; 2016;27:315-e78. https://doi.org/10.1111/vde.12324
5. López A, Van Hoorebeke S, Maes D, Health H, Chiers K, Meyns T, et al. Porcine ulcerative dermatitis syndrome in sows: a form of vesicular cutaneous lupus erythematosus? Veterinary Record. 2009;165:501–6.
🔒 Contenido exclusivo para usuarios registrados.
Regístrate gratis para acceder a este post y a muchos más contenidos especializados. Solo te llevará un minuto y tendrás acceso inmediato.
Iniciar sesiónRegístrate en porciNews
REGISTRARME









